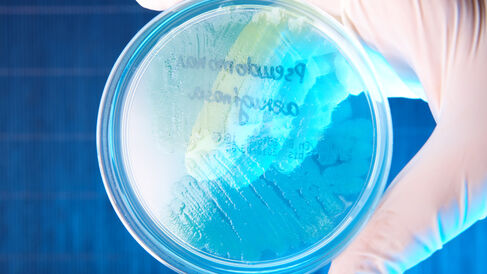

Alumni Festival 2020
The 30th annual University of Cambridge Alumni Festival took place from Thursday 17th September to Saturday 26th September 2020. Professor Paul Dupree and Dr Martin Welch both gave talks to University alumni and members of the general public over Zoom due to the coronavirus (COVID-19) pandemic.
Sugary solutions for our health and the environment
Wood, straw and compostable waste are, perhaps surprisingly, full of sugar. In this talk, Professor Paul Dupree discussed how plants use sugars to grow, and introduced some recently emerging ideas that studying plant sugars may help us tackle issues from plastic pollution to mental health. The talk was followed by a Q&A session.
- Speaker: Professor Paul Dupree
- Date: Friday 18th September
- Time: 13:00-13:45
- Location: Zoom
Antibiotic resistance and the rise of the 'superbug'
We've all heard the doom and gloom about antibiotic resistance, 'pharmageddon', and the rise of 'superbugs'. But what lies behind this story, and more importantly, how (if at all) will it affect you? In spite of the lurid newspaper reports, you may be quite surprised. The talk was followed by a Q&A session.
- Speaker: Dr Martin Welch
- Date: Saturday 26th September
- Time: 14:00-14:45
- Location: Zoom